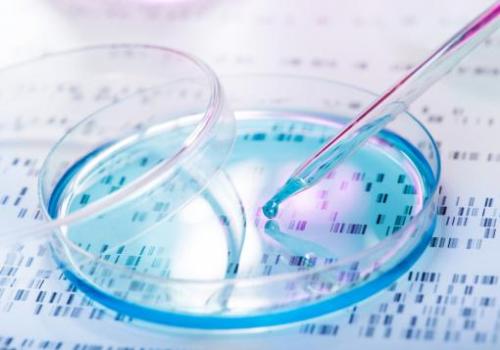

As science’s ability to detect and sequence DNA improves, it becomes increasingly evident that creation is embedded with specific and complex coded messages that didn’t just appear out of nowhere.
Source: DNA reveals God’s coded messages – Science & Tech – WORLD
Categories: Articole de interes general
Leave a comment